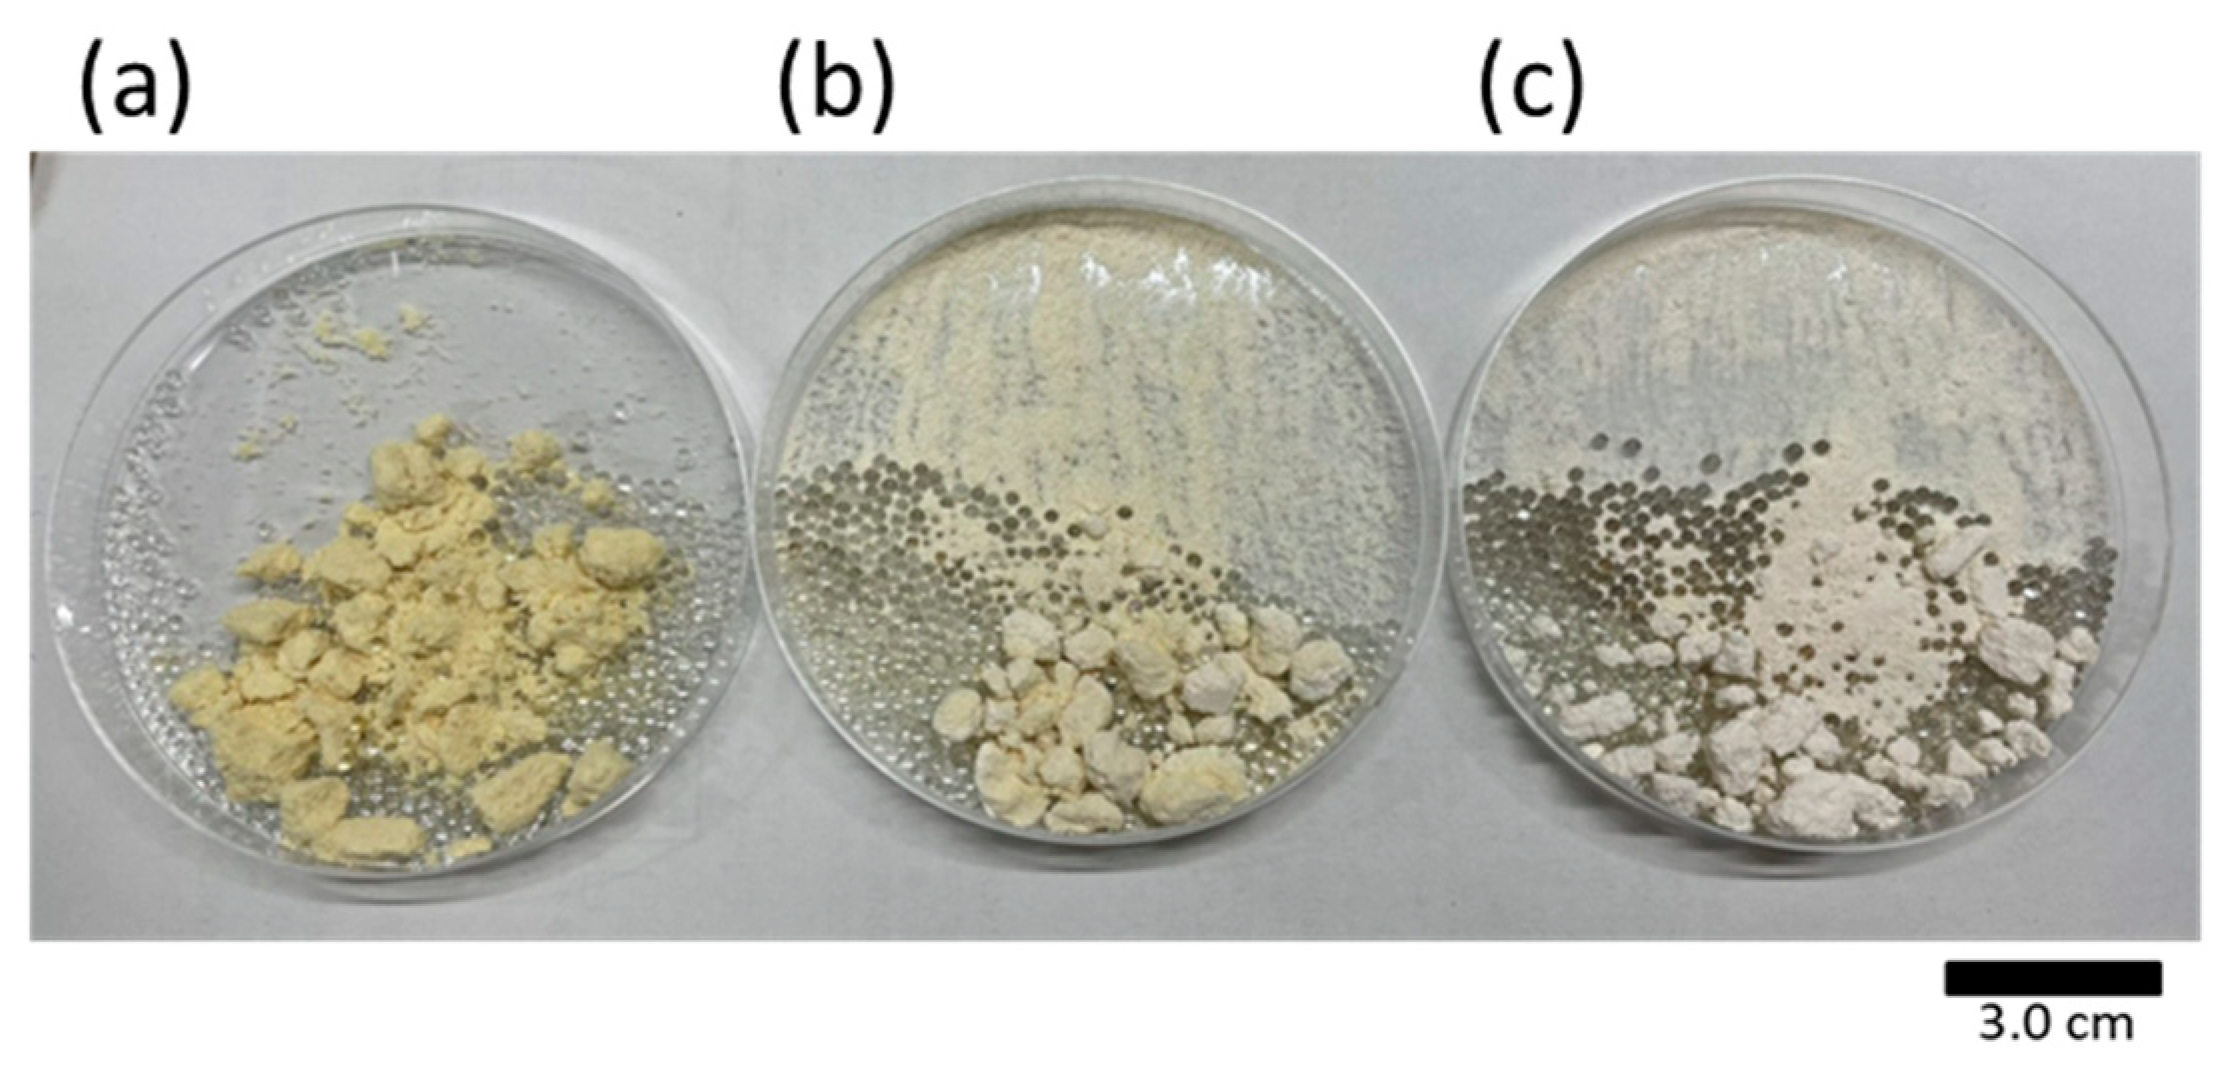
Foods 10 01223 g007

Enhancement of Lipid Extraction from Soya Bean by Addition of Dimethyl Ether as Entrainer into Supercritical Carbon Dioxide
Abstract
1. Introduction
2. Materials and Methods
2.1. Samples and Chemicals
2.2. SC-CO2/DME Extraction
2.3. Analysis
2.3.1. Fourier Transform Infrared Spectroscopy (FTIR) Spectra
2.3.2. Thin-Layer Chromatography (TLC)
2.3.3. Elemental Analysis
2.3.4. Fatty Acid Analysis
3. Results
3.1. Effect of Extraction Conditions on Lipid Extraction
3.2. Properties of the Extracts and Residue
4. Discussion
4.1. Effect of Extraction Conditions on Lipid Extraction
4.2. Properties of the Extracts and Residue
5. Conclusions
Author Contributions
Funding
Institutional Review Board Statement
Informed Consent Statement
Conflicts of Interest
References
- Ono, M.; Kawamoto, Y.; Uemori, C.; Diono, W.; Kanda, H.; Goto, M. Extraction of phytochemicals from grains of paradise using supercritical carbon dioxide. Eng. J. 2017, 21, 53–64. [Google Scholar] [CrossRef][Green Version]
- Yamamoto, N.; Murakami, K.; Kimthet, C.; Wahyudiono, W.; Onwona-Agyeman, S.; Kanda, H.; Goto, M. Lipids from Vitellaria paradoxa Gaertn seeds by supercritical CO2: Extraction and optimization of parameters by response surface methodology. Eng. J. 2018, 22, 31–44. [Google Scholar] [CrossRef]
- Chhouk, K.; Uemori, C.; Wahyudiono; Kanda, H.; Goto, M. Extraction of phenolic compounds and antioxidant activity from garlic husk using carbon dioxide expanded ethanol. Chem. Eng. Process. 2017, 117, 113–119. [Google Scholar] [CrossRef]
- Nerome, H.; Ito, M.; Machmudah, S.; Kanda, H.; Goto, M. Extraction of phytochemicals from saffron by supercritical carbon dioxide with water and methanol as entrainer. J. Supercrit. Fluids. 2016, 107, 377–383. [Google Scholar] [CrossRef]
- Wu, J.; Zhou, Y.; Lemmon, E.W. An equation of state for the thermodynamic properties of dimethyl ether. J. Phys. Chem. Ref. Data. 2011, 40, 023104. [Google Scholar] [CrossRef]
- Oshita, K.; Takaoka, M.; Kitade, S.; Takeda, N.; Kanda, H.; Makino, H.; Matsumoto, T.; Morisawa, S. Extraction of PCBs and water from river sediment using liquefied dimethyl ether as an extractant. Chemosphere 2010, 78, 1148–1154. [Google Scholar] [CrossRef] [PubMed]
- Oshita, K.; Toda, S.; Takaoka, M.; Kanda, H.; Fujimori, T.; Matsukawa, K.; Fujiwara, T. Solid fuel production from cattle manure by dewatering using liquefied dimethyl ether. Fuel 2015, 159, 7–14. [Google Scholar] [CrossRef]
- Hoshino, R.; Ogawa, M.; Murakami, K.; Wahyudiono; Kanda, H.; Goto, M. Extraction of lipids from wet Arthrospira platensis by liquefied dimethyl ether. Solvent Extr. Res. Dev. Jpn. 2017, 24, 47–60. [Google Scholar] [CrossRef]
- Kanda, H.; Wahyudiono; Machmudah, S.; Goto, M. Direct extraction of lutein from wet macroalgae by liquefied dimethyl ether without any pretreatment. ACS Omega 2020, 5, 24005–24010. [Google Scholar] [CrossRef] [PubMed]
- Hoshino, R.; Murakami, K.; Wahyudiono; Machmudah, S.; Okita, Y.; Ohashi, E.; Kanda, H.; Goto, M. Economical wet extraction of lipid from labyrinthulea Aurantiochytrium limacinum by using liquefied dimethyl ether. Eng. J. 2016, 20, 145–153. [Google Scholar] [CrossRef]
- Panel on Food Contact Materials, Enzymes, Flavourings and Processing Aids. Scientific Opinion on the safety of use of dimethyl ether as an extraction solvent under the intended conditions of use and the proposed maximum residual limits. EFSA J. 2015, 13, 4174. [Google Scholar] [CrossRef]
- Varlet, V.; Smith, F.; Augsburger, M. New trends in the kitchen: Propellants assessment of edible food aerosol sprays used on food. Food Chem. 2014, 142, 311–317. [Google Scholar] [CrossRef] [PubMed]
- Kanda, H.; Ando, D.; Hoshino, R.; Yamamoto, T.; Wahyudiono; Suzuki, S.; Shinohara, S.; Goto, M. Surfactant-free decellularization of porcine aortic tissue by subcritical dimethyl ether. ACS Omega 2021, 6, 13417–13425. [Google Scholar] [CrossRef]
- Calm, J.M.; Hourahan, G. Refrigerant Data Update. HPAC Eng. 2007, 79, 50–64. [Google Scholar]
- Subratti, A.; Lalgee, L.J.; Jalsa, N.K. Liquefied dimethyl ether (DME) as a green solvent in chemical reactions: Synthesis of O-alkyl trichloroacetimidates. Sustain. Chem. Pharm. 2018, 9, 46–50. [Google Scholar] [CrossRef]
- Catchpole, O.J.; Grey, J.B.; Perry, N.B.; Burgess, E.J.; Redmond, W.A.; Porter, N.G. Extraction of chili, black pepper, and ginger with near-critical CO2, propane, and dimethyl ether: Analysis of the extracts by quantitative nuclear magnetic resonance. J. Agric. Food Chem. 2003, 51, 4853–4860. [Google Scholar] [CrossRef] [PubMed]
- Tatamitani, Y.; Liu, B.; Shimada, J.; Ogata, T.; Ottaviani, P.; Maris, A.; Caminati, W.; Alonso, J.L. Weak, improper, C−O···H−C hydrogen bonds in the dimethyl ether dimer. J. Am. Chem. Soc. 2002, 124, 11–2739. [Google Scholar] [CrossRef]
- Lee, M.C.; Seo, S.B.; Chung, J.H.; Joo, Y.J.; Ahn, D.H. Industrial gas turbine combustion performance test of DME to use as an alternative fuel for power generation. Fuel 2009, 88, 657–662. [Google Scholar] [CrossRef]
- Kondo, S.; Takizawa, K.; Takahashi, A.; Tokuhashi, K. Extended Le Chatelier’s formula for carbon dioxide dilution effect on flammability limits. J. Hazard. Mater. 2006, 138, 1–8. [Google Scholar] [CrossRef] [PubMed]
- Tallon, S.; Fenton, K. The solubility of water in mixtures of dimethyl ether and carbon dioxide. Fluid Phase Equilib. 2010, 298, 60–66. [Google Scholar] [CrossRef]
- Ginderen, P.V.; Herrebout, W.A.; van der Veken, B.J. van der Waals complex of dimethyl ether with carbon dioxide. J. Phys. Chem. A 2003, 107, 28–5391. [Google Scholar] [CrossRef]
- Mahmood, C.L.; Xin, S.H.; Gong, P.; Lee, J.H.; Li, G.; Park, C.B. Dimethyl ether’s plasticizing effect on carbon dioxide solubility in polystyrene. Polymer 2016, 97, 95–103. [Google Scholar] [CrossRef]
- Kanda, H.; Li, P.; Yoshimura, T.; Okada, S. Wet extraction of hydrocarbons from Botryococcus braunii by dimethyl ether as compared with dry extraction by hexane. Fuel 2013, 105, 535–539. [Google Scholar] [CrossRef]
- Friedrich, J.P.; List, G.R. Characterization of soya bean oil extracted by supercritical carbon dioxide and hexane. J. Agric. Food Chem. 1982, 30, 192–193. [Google Scholar] [CrossRef]
- Friedrich, J.P.; Pryde, E.H. Supercritical CO2 extraction of lipid-bearing materials and characterization of the products. J. Am. Oil Chem. Soc. 1984, 61, 223–228. [Google Scholar] [CrossRef]
- Hong, I.K.; Rho, S.W.; Lee, K.S.; Lee, W.H.; Yoo, K.P. Modeling of soya bean oil bed extraction with supercritical carbon dioxide. Korean J. Chem. Eng. 1990, 7, 40–46. [Google Scholar] [CrossRef]
- Taylor, S.L.; Eller, F.J.; King, J.W. A comparison of oil and fat content in oilseeds and ground beef-using supercritical fluid extraction and related analytical techniques. Food Res. Int. 1997, 30, 365–370. [Google Scholar] [CrossRef]
- Brühl, L.; Matthäus, B. Extraction of oilseeds by SFE—A comparison with other methods for the determination of the oil content. Fresenius J. Anal. Chem. 1999, 364, 631–634. [Google Scholar] [CrossRef]
- Nodar, M.D.; Gómez, A.M.; Martínez de la Ossa, E. Characterisation and process development of supercritical fluid extraction of soya bean oil. Food Sci. Technol. Int. 2002, 8, 337–341. [Google Scholar] [CrossRef]
- Artz, W.E.; Kinyanjui, T.; Cheryan, M. Solubility optimization of oil components in supercritical carbon dioxide. J. Food Lipids 2005, 12, 91–102. [Google Scholar] [CrossRef]
- Jokić, S.; Zeković, Z.; Vidović, S.; Sudar, R.; Nemet, I.; Bilić, M.; Velić, D. Supercritical CO2 extraction of soya bean oil: Process optimisation and triacylglycerol composition. Int. J. Food Sci. Technol. 2010, 45, 1939–1946. [Google Scholar] [CrossRef]
- Sakuragi, K.; Li, P.; Otaka, M.; Makino, H. Recovery of bio-oil from industrial food waste by liquefied dimethyl ether for biodiesel production. Energies 2016, 9, 106. [Google Scholar] [CrossRef]
- Honda, M.; Ishimaru, T.; Itabashi, Y. Lipid classes, fatty acid composition, and glycerolipid molecular species of the red alga Gracilaria vermiculophylla, a prostaglandin-producing Seaweed. J. Oleo Sci. 2016, 65, 723–732. [Google Scholar] [CrossRef]
- Kanda, H.; Hoshino, R.; Murakami, K.; Wahyudiono; Zheng, Q.; Goto, M. Lipid extraction from microalgae covered with biomineralized cell walls using liquefied dimethyl ether. Fuel 2020, 262, 116590. [Google Scholar] [CrossRef]
- Liu, H.M.; Wang, F.Y.; Liu, Y.L. Hot-compressed water extraction of polysaccharides from soy hulls. Food Chem. 2016, 202, 104–109. [Google Scholar] [CrossRef] [PubMed]
- Kodama, S.; Shoda, T.; Siti, M.; Wahyudiono; Kanda, H.; Goto, M. Enhancing pressurized water extraction of β-glucan from barley grain by adding CO2 under hydrothermal conditions. Chem. Eng. Process. 2015, 97, 45–54. [Google Scholar] [CrossRef]
- Halim, R.; Danquah, M.K.; Webley, P.A. Extraction of oil from microalgae for biodiesel production: A review. Biotechnol. Adv. 2011, 30, 709–732. [Google Scholar] [CrossRef]
- Takahashi, Y.; Itabashi, Y.; Suzuki, M.; Kuksis, A. Determination of stereochemical configuration of the glycerol moieties in glycoglycerolipids by chiral phase high-performance liquid chromatography. Lipids 2001, 36, 741–748. [Google Scholar] [CrossRef]
- Kanda, H.; Oishi, K.; Machmudah, S.; Wahyudiono; Goto, M. Ethanol-free extraction of resveratrol and its glycoside from Japanese knotweed rhizome by liquefied dimethyl ether without pretreatments. Asia-Pac. J. Chem. Eng. 2021, 16, e2600. [Google Scholar] [CrossRef]
- Sistla, Y.S.; Jain, L.; Khanna, A. Validation and prediction of solubility parameters of ionic liquids for CO2 capture. Sep. Purif. Technol. 2012, 97, 51–64. [Google Scholar] [CrossRef]
- Hansen, C.M. The three dimensional solubility parameter, key to paint component affinities; solvents, plasticizers, polymers and resins. J. Paint Technol. 1967, 39, 104–117. [Google Scholar]

| Moisture | Protein | Fat | Carbohydrate | Ash | |
|---|---|---|---|---|---|
| % Wet basis | 9.86 | 40.39 | 20.58 | 25.09 | 4.08 |
| Dry Ash Free (wt%) | Carbon (±0.3) | Hydrogen (±0.1) | Nitrogen (±0.2) | Oxygen (±0.6) |
|---|---|---|---|---|
| SC-CO2 | 77.5 | 12.0 | 0.2 | 10.3 1 |
| SC-CO2 with DME | 77.3 | 12.1 | 0.0 | 10.6 1 |
| TG (C18:2) | 77.6 2 | 11.5 2 | 10.9 2 | |
| MGDG (C18:2) | 71.6 2 | 11.0 2 | 17.4 2 | |
| PC (C18:2) | 10.6 2 | 68.3 2 | 21.1 2 |
| Fatty Acid (%) | C16:0 (±0.4) | C16:1 (±0.02) | C18:0 (±0.1) | C18:1 (±0.2) | C18:2 (±0.8) | C20:0 (±0.3) | Others (±0.2) |
|---|---|---|---|---|---|---|---|
| SC-CO2 1 | 18.4 | 0.3 | 10.8 | 20.6 | 47.3 | 1.6 | 1.1 |
| SC-CO2 with DME 1 | 21.0 | 0.4 | 10.0 | 20.0 | 46.6 | 1.3 | 0.8 |
| Fatty Acid (mg/g) | C16:0 (±3.6) | C16:1 (±0.2) | C18:0 (±0.6) | C18:1 (±1.7) | C18:2 (±5.5) | C20:0 (±1.5) | Others (±1.3) |
| SC-CO2 | 106 | 1.7 | 62.0 | 118 | 273 | 9.0 | 6.0 |
| SC-CO2 with DME | 150 | 2.6 | 71.5 | 143 | 335 | 9.0 | 5.9 |
Publisher’s Note: MDPI stays neutral with regard to jurisdictional claims in published maps and institutional affiliations. |
© 2021 by the authors. Licensee MDPI, Basel, Switzerland. This article is an open access article distributed under the terms and conditions of the Creative Commons Attribution (CC BY) license (https://creativecommons.org/licenses/by/4.0/).
Share and Cite
Kanda, H.; Fukuta, Y.; Wahyudiono; Goto, M. Enhancement of Lipid Extraction from Soya Bean by Addition of Dimethyl Ether as Entrainer into Supercritical Carbon Dioxide. Foods 2021, 10, 1223. https://doi.org/10.3390/foods10061223
Kanda H, Fukuta Y, Wahyudiono, Goto M. Enhancement of Lipid Extraction from Soya Bean by Addition of Dimethyl Ether as Entrainer into Supercritical Carbon Dioxide. Foods. 2021; 10(6):1223. https://doi.org/10.3390/foods10061223
Chicago/Turabian StyleKanda, Hideki, Yuji Fukuta, Wahyudiono, and Motonobu Goto. 2021. "Enhancement of Lipid Extraction from Soya Bean by Addition of Dimethyl Ether as Entrainer into Supercritical Carbon Dioxide" Foods 10, no. 6: 1223. https://doi.org/10.3390/foods10061223
APA StyleKanda, H., Fukuta, Y., Wahyudiono, & Goto, M. (2021). Enhancement of Lipid Extraction from Soya Bean by Addition of Dimethyl Ether as Entrainer into Supercritical Carbon Dioxide. Foods, 10(6), 1223. https://doi.org/10.3390/foods10061223








